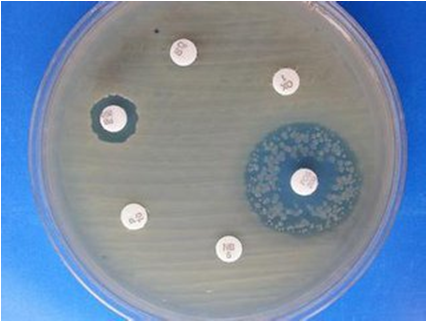

-
1
-
2 测验

B-内酰胺类抗生素
结构中都含有b-内酰胺环
包括:
1、青霉素类抗生素
2、头孢菌素类抗生素
3、非典型的b-内酰胺类抗生素
青霉素是应用最早的抗生素,因在二战期间挽救了大量生命,与原子弹、雷达并称为第二次世界大战中的三大发明。
青霉素是应用最早的抗生素,因在二战期间挽救了大量生命,与原子弹、雷达并称为第二次世界大战中的三大发明。
英国首相丘吉尔曾经这样说:“青霉素是二战时最伟大的发明。”
青霉素的发现
1928年,英国微生物学家弗莱明意外地在他的实验室里发现青霉菌能分泌一种杀死许多其它有害细菌的物质,并命名为“青霉素”,1929年在发表的研究论文《关于霉菌培养的杀菌作用》中指出,青霉素将会有重要的用途。
1939年,澳大利亚人瓦弗洛里和德国钱恩,重复了弗莱明的工作,证实了他的结果,然后用冷冻干燥法提取了青霉素晶体。1941年给病人使用成功。在英美政府的鼓励下,很快找到大规模生产青霉素的方法,1944年英美公开在医疗中使用,1945年以后,青霉素遍及全世界。1945年,弗莱明、弗洛里和钱恩共获诺贝尔生理学及医学奖。

青霉素类抗生素
天然青霉素G
天然青霉素有G、K、X、F等,相比青霉素G的性质稳定,含量最高,作用最强,临床常用。
◆青霉素G为不稳定的有机酸,常用其钠盐或钾盐,干燥粉末室温中可保存数年,水溶液室温放置24h大部分分解失效,使抗菌活性下降,并产生具有抗原性的青霉噻唑、青霉烯酸、6-APA聚合物,易致敏。
◆临床须现用现配。易被酸、碱、氧化剂、金属离子破坏使抗菌作用减弱或消失。不耐酸,口服易被破坏,临床一般采用肌内注射、静脉滴注法给药,吸收快而完全,主要分布细胞外液,且广泛分布于关节腔、浆膜腔、间质液、淋巴液、中耳液及各组织,不易透过血脑屏障,但脑膜炎时可达有效浓度。
◆不被代谢,主要以原形经尿排泄,90%经肾小管分泌。丙磺舒与其竞争肾小管分泌,使其排泄减慢作用时间延长。
抗菌作用与抗菌谱 (三菌一体)
对繁殖期敏感菌有强大的杀灭作用,窄谱
G+球菌:溶血性链球菌、草绿色链球菌、肺炎链球菌、不产酶金黄色葡萄球菌
G+杆菌:白喉棒状杆菌、炭疽芽孢杆菌、 厌氧杆菌(破伤风杆菌、产气夹膜杆菌)◆等
G-球菌:脑膜炎奈瑟菌、淋病奈瑟菌
放线菌
螺旋体:梅毒螺旋体 钩端螺旋体 回归热螺旋体


抗菌机理
青霉素与敏感菌胞浆膜上青霉素结合蛋白(PBPs)结合,抑制转肽酶活性,阻止粘肽合成,造成细胞壁缺损,由于敏感菌菌体内渗透压高,使水分子不断内渗,以致菌体膨胀破裂死亡。
——繁殖期杀菌药
作用特点
繁殖期作用强于静止期
球菌、G+杆细胞壁粘肽含量>G-
对哺乳动物(无细胞壁毒性小)



耐药性
◆青霉素对β-内酰胺酶不稳定,金黄色葡萄球菌等产酶细菌对青霉素耐药
◆药物作用的靶位变化
◆PBPs亲和力减小
◆细胞壁和细胞膜通透性的改变
药物外排
自溶酶的减少

临床应用
首选于敏感G+球、G+杆、G-球菌、螺旋体感染
G+球菌感染:
肺炎链球菌感染:肺炎、中耳炎
溶血性链球菌感染:咽炎、扁桃体炎、猩红热
草绿色链球菌感染:心内膜炎
化脓性链球菌感染:咽炎、扁桃体炎、猩红热、丹毒
不产酶葡萄球菌感染
G+杆菌感染(破伤风、白喉、炭疽、气性坏疽等)应合用相应的抗毒素中和外毒素
G-球菌感染(脑膜炎、淋病)
放线菌病
螺旋体感染(钩端螺旋体病、梅毒、回归热)
不良反应
过敏反应:1%~10%
慢性——注射后1~2周荨麻疹、药疹、黏膜水肿、关节肿痛
急性——注射后5~20分钟,过敏性休克
面色苍白、冷汗、胸闷、呼吸困难、脉搏细弱、BP低,惊厥、昏迷、意识丧失如不及时抢救,可因呼吸、循环衰竭危及生命。
过敏性休克可在皮肤过敏试验中或注射后数秒钟至数分钟内或在连续用药过程中发生。为防止过敏性休克的发生,应用青霉素时必须注意采取防治措施。
青霉素在应用之前都要?
①询问病史(用药史、过敏史、家族史);
②皮试(阳性率与实际阳性率相符率达98.96%)重新皮试
③溶液现配(过敏原: 制剂/仓储中降解物青霉噻唑、青霉烯酸)
④准备抢救药物(肾上腺素、激素、抗H1药等)
迅速使患者平卧,皮下或者静脉注射0.5~1mg肾上腺素,可合用激素、抗H1药,另外辅助人工呼吸、输液、升压等

不良反应
局部刺激:肌注钾盐可产生局部疼痛、硬结、周围神经炎
赫氏反应:梅毒或钩端螺旋体病患者在接受首剂青霉素或其他抗菌药物治疗后,可因大量钩端螺旋体被杀死而释放毒素引起临床症状的加重反应,常表现为全身不适、高热、大汗淋漓、寒战、咽痛、头痛、血压下降、皮肤感染病变扩大、恶化等,严重者可危机生命。称赫氏反应。
一般在用药后6~8h出现,随着治疗进程的继续上述反应消失、缓解,表现为一过性、暂时性"恶化",此反应因发现者而命名。
故青霉素治疗钩体病时,宜首剂小剂量和分次给药。
天然青霉素的特点 ?
优点:高效、低毒、价廉
缺点:抗菌谱窄、用药不方便(不耐酸)、易耐药(不耐酶)、易过敏
为了改善这些缺点对青霉素G进行了结构的修饰,从而得到了一系列半合成青霉素。其抗菌活性不及青霉素G,作用机理、不良反应与青霉素相似,且与青霉素存在交叉过敏反应。
半合成青霉素
1. 口服青霉素类:苯氧青霉素类注射口服
青霉素Ⅴ (penicillin V)
非奈西林 (phenethicillin)
特点:耐酸,不耐酶 用于G+菌轻症感染
2. 耐酶青霉素类:异恶唑类青霉素注射口服
苯唑西林 (oxacillin)
氯唑西林 (cloxacillin)
双氯西林 (dicloxacillin) 作用最强
氟氯西林 (flucloxacillin)
特点:耐酶,耐酸
主要用于耐青霉素 G的金葡菌感染
3. 广谱青霉素类注射口服
氨苄西林 (ampicillin) 、匹氨西林 (pivampicillin)
阿莫西林 (amoxycillin)、海他西林
特点:广谱(G+菌弱于青,G-杆菌较强绿脓杆菌无效),耐酸,不耐酶
4. 抗绿脓杆菌广谱青霉素类注射
羧苄西林 (carbenicillin)、 磺苄西林 (sulbenicillin)
替卡西林 (ticarcillin)
呋苄西林 (flubenicillin) 、阿洛西林 (azlocillin)
哌拉西林 (piperacillin)、 美洛西林 (mezlocillin)
特点:广谱(G+与青类似,G-杆菌、绿脓杆菌较强)、 不耐酶、不耐酸
5. 抗G-菌青霉素
美西林 (mecillinam) 注射
匹美西林 (pivmecillinam)口服
替莫西林 (temocillin)
特点:窄谱( G-菌强,绿脓杆菌无效)、耐酶(G-菌产生的酶稳定)
主要用于G-杆菌引起的泌尿道感染和软组织感染
头孢菌素类抗生素
母核——7-氨基头孢烷酸(7-ACA)
与青霉素类相比:
1. 作用机制相同
2. 对b-内酰胺酶稳定性高,不易产生耐药
3. 抗菌谱广,抗菌作用强
4. 过敏反应少,与青霉素类有部分交叉过敏反应 (5~10%)
一类高效、低毒、临床广泛应用的重要抗生素。
体内过程
1. 部分耐酸,可口服;一般口服吸收差需肌注或静注
2. 分布很广,广泛透入各种组织,部分通过血脑屏障。
3. 大部分以原形经肾脏排泄 ,头孢哌酮、头孢曲松、头孢克肟主要经肝胆排泄
药物发展趋势

三代头孢中的四大金刚:头孢哌酮、曲松、噻肟、他啶
箭头方向为增强

1. 过敏反应:
2. 肾毒性:1、2代大剂量使用
3. 菌群失调症即二重感染:3、4代长期使用
4. 出血(+VK预防):哌酮、孟多、呋辛
低凝血酶原血症、血小板减少
5.双硫仑样反应
头孢唑林、头孢哌酮、头孢尼西、头孢替安、头孢孟多、头孢曲松、头孢拉定、头孢米诺、头孢克洛、头孢甲肟、头孢匹胺(唑派你替美酒梦曲拉米克家安)

双硫仑样反应
乙醇进入体内,90% 先在肝脏内经乙醇脱氢酶作用转化为乙醛,乙醛再经肝细胞线粒体内乙醛脱氢酶作用,转化为乙酰辅酶 A 和乙酸进入三羧酸循环,最后转化为水和二氧化碳排出。双硫仑可抑制乙醛脱氢酶、多巴胺β羟化酶,使乙醛不能转化为乙酸,致使体内乙醛蓄积,产生不适。(皮肤潮红、头晕、头痛、呼吸困难、晕厥、口中有大蒜气味,还可出现心动过速、血压下降,严重者休克、惊厥、急性心力衰竭、心肌梗死甚至死亡)
在服用3位有甲硫杂环的头孢菌素药物期间及之后5~ 7d 内饮酒、服用含乙醇的药物、食物甚至外用乙醇,均可抑制乙醛脱氢酶,而使乙醛代谢为乙酸受阻,中间产物乙醛浓度急剧升高,积蓄体内而产生双硫仑样反应。
“中国头孢第一人”安静娴
我国著名化学制药专家,中国制药工业企业第一位工程院院士,东北制药高级工程师及终身员工安静娴。

1952年从北京大学毕业后,即进入东北制药总厂工作。20世纪80年代,组织和主持头孢类药物、脑血管用药等产品的研究开发,取得显著的经济效益和社会效益,其中头孢噻肟钠、头孢三嗪、头孢他啶、头孢氨苄的成功开发,填补了国内企业头孢类抗生素的生产空白。
安静娴在1997年当选为中国工程院院士。2015年7月10日在北京逝世。
非典型b-内酰胺类抗生素
1.头霉素类:头孢西丁 、头孢美唑、头孢替坦(双硫仑样反应)
抗菌谱广,对G-杆菌尤其肠杆菌科作用强、厌氧菌,对β-内酰胺酶稳定
2.碳青霉烯类:美罗培南
亚胺培南+ 西司他丁(肾脱氢肽酶抑制剂)→泰能
抗菌谱最广,G+菌、G-菌、厌氧菌强效,对β-内酰胺酶稳定,且有抑制β-内酰胺酶的作用
3.氧头孢烯类:拉氧头孢、氟氧头孢
抗菌谱抗菌活性与3代头孢菌素相似,多种G-杆菌、厌氧菌作用强。可引起凝血酶原减少、血小板减少而致出血,且有双硫仑样反应,较少用。氟氧头孢未发现此反应。
4.单环β-内酰胺类:氨曲南
抗菌谱窄,仅对需氧的G-杆菌强,对G-杆菌产生的酶稳定,氨基糖苷类的替代药,低毒无过敏(与青霉素、头孢无交叉过敏),可用于对青霉素过敏者。
5.β-内酰胺酶抑制剂:
高效低毒延缓耐药性:
克拉维酸 +阿莫西林→奥格门汀
克拉维酸+替卡西林→泰门汀
舒巴坦 +氨苄西林→优立新
舒巴坦+头孢哌酮→舒普深
三唑巴坦+哌拉西林→特治新
抗菌作用弱,但与β-内酰胺类抗生素联合应用可保护β-内酰胺环免受水解而增强抗菌作用。


